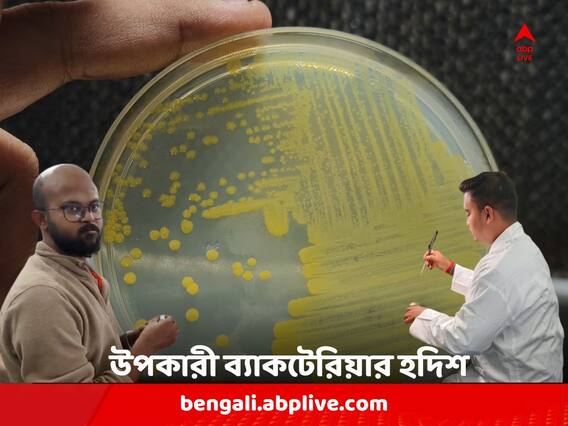

ভাস্কর মুখোপাধ্যায়, বোলপুর : উপকারী ব্যাকটেরিয়া আবিষ্কার করল বিশ্বভারতীর উদ্ভিদবিদ্যা বিভাগ। এই ব্যাকটেরিয়া মূলত ধান চাষে অত্যন্ত সহায়ক হবে ৷ ব্যাকটেরিয়াটির নামকরণ করা হয়েছে রবীন্দ্রনাথ ও রথীন্দ্রনাথ ঠাকুরের নামে। ইতিমধ্যে বিশ্বভারতীর এই আবিষ্কারকে স্বীকৃতি দিয়েছে অ্যাসোসিয়েশন অফ মাইক্রোবায়োলজিস্ট অফ ইন্ডিয়া (এএমআই)।
কৃষিকাজকে সমৃদ্ধ করতে গুরুদেব রবীন্দ্রনাথ ঠাকুর কৃষি গবেষণার উপর জোর দিয়েছিলেন ৷ তাই তিনি শ্রীনিকেতন প্রতিষ্ঠ করেছিলেন ৷ এমনকী, নিজের ছেলে রথীন্দ্রনাথ ঠাকুরকে কৃষিবিদ্যা পাঠ নিতে বিদেশে পাঠিয়েছিলেন ৷ পরবর্তীকালে বিশ্বভারতীর প্রথম উপাচার্য হন রথীন্দ্রনাথ ঠাকুর ৷ তাঁর হাত ধরে শুরু হয় কৃষি গবেষণার নানান কাজ।
কৃষিক্ষেত্রে ফলন বৃদ্ধিতে সবচেয়ে গুরুত্বপূর্ণ উপাদান হল- নাইট্রোজেন, ফসফরাস ও পটাশিয়াম। এই তিনটি উপাদানকে একত্রে বলে এনপিকে ৷ মাটি থেকে উদ্ভিদ এই উপাদান সংগ্রহ করে ৷ কিন্তু, অনেক ক্ষেত্রে মাটিতে এর যোগান কম থাকলে বাজারজাত উপাদানগুলি দিতে হয় চাষিদের ৷
সার্বিক বিষয় মাথায় রেখেই, বিশ্বভারতীর উদ্ভিদবিদ্যা বিভাগ একটু নতুন প্রজাতির উপকারী ব্যাকটেরিয়া আবিষ্কার করেছে। নাম 'প্যান্টোইয়া টেগোরী' ( Pantoea Tagorei )। উদ্ভিদবিদ্যা বিভাগের অনুজীববিদ্যার অধ্যাপক ডঃ বুম্বা দাম তাঁর ৫ পড়ুয়া রাজু বিশ্বাস, অরিজিৎ মিশ্র, অভিনব চক্রবর্তী, পূজা মুখোপাধ্যায় ও সন্দীপ ঘোষকে সঙ্গে নিয়ে এই ব্যাকটেরিয়া আবিষ্কার করেন ৷ মূলত ধান চাষের অত্যন্ত সহায়ক অনুজীব। এছাড়া, লঙ্কা ও মটর চাষের পক্ষেও উপকারী এই ব্যাকটেরিয়া। এর কাজ, মাটি থেকে অতি সহজেই পটাশিয়াম সংগ্রহ করে উদ্ভিদের বৃদ্ধিতে সহযোগিতা করা ৷ ৬ জনের এই দল গবেষণা করতে করতে শান্তিনিকেতনের সোনাঝুরি, পরে ঝাড়খণ্ডের ঝরিয়া কয়লা খনি অঞ্চলের মাটি থেকে এই ব্যাকটেরিয়ার সন্ধান পান ৷ কৃষিক্ষেত্রে তাঁদের ভাবনা, অবদানকে স্মরণ করে গুরুদেব রবীন্দ্রনাথ ঠাকুর ও রথীন্দ্রনাথ ঠাকুরের নামে ব্যাকটেরিয়াটির নামকরণ করা হয়েছে। ইতিমধ্যেই বিশ্বভারতীর এই আবিষ্কারকে স্বীকৃতি দিয়েছে এএমআই।
বিশ্বভারতীর উদ্ভিদবিদ্যা বিভাগের অধ্যাপক ডঃ বুম্বা দাম বলেন, "এই ব্যাকটেরিয়া চাষের পক্ষে খুবই উপকারী। আমরা আগে পরীক্ষামূলকভাবে চাষ করে দেখেওছি ৷ সদ্য শান্তিনিকেতন ওয়ার্ল্ড হেরিটেজ তকমা পেয়েছে। তাই আমরা এই ব্যাকটেরিয়ার নাম গুরুদেব রবীন্দ্রনাথ ঠাকুর ও বিশ্বভারতীর প্রথম উপাচার্য রথীন্দ্রনাথ ঠাকুরের নামে রেখেছি। লিভিং কোনও অর্গানিজমের নাম টেগরের নামে। আমার গবেষক পড়ুয়ারাও খুব মন দিয়ে কাজ করেছে এক্ষেত্রে।"
গবেষক পড়ুয়াদের মধ্যে রাজু বিশ্বাস ও অভিজিৎ মিশ্র বলেন, "এটা বিশ্বভারতীর আবিষ্কার। এই ব্যাকটেরিয়া ব্যবহারের ফলে চাষিরা উপকৃত হবেন ৷ সারের খরচ অনেক গুণ কমবে ৷ এই ব্যাকটেরিয়া মাটি থেকে সহজেই পটাশিয়াম সংগ্রহ করে উদ্ভিদের বৃদ্ধিতে সহযোগিতা করতে পারে ৷ আমরা ঝরিয়ার কয়লা খনি অঞ্চল থেকে এই ব্যাকটেরিয়ার সন্ধান পেয়েছি।"